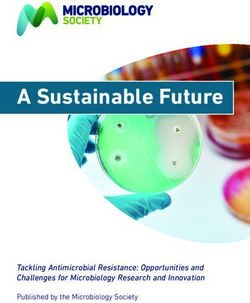
A Sustainable Future - Tackling Antimicrobial Resistance: Opportunities and Challenges for Microbiology Research and Innovation - Microbiology Society

DART 2020 2nd Interim Report 2017 - G20 Research Group
←
→
Page content transcription
If your browser does not render page correctly, please read the page content below
DART 2020 – 2nd Interim Report 2017 3 Table of contents Foreword 5 Introduction 7 GOAL 1: Strengthening the One Health approach nationally and internationally 8 GOAL 2: Recognising changes in resistance at an early stage 13 GOAL 3: Retaining and improving therapy options 15 GOAL 4: Breaking chains of infection early and avoiding infections 18 GOAL 5: Raising awareness and strengthening skills 22 GOAL 6: Supporting research and development 24 Concluding remarks 32
DART 2020 – 2nd Interim Report 2017 5 Foreword The broader significance of antibiotics extends far beyond the treatment of bacterial infections. Many therapeutic approaches in modern medicine, among them cancer treatment, complex surgery or care of premature infants, crucially depend on the availability of effective antibiotics. The global rise in antimicrobial resistance threatens the survival of various treatment options. In 2015, the German Federal Cabinet adopted the German Antimicrobial Re- sistance Strategy (DART 2020) to address this problem and pool the measures required to reduce antimicrobial resistance. The strategy applies equally to human medicine, veterinary medicine and agriculture. All stakeholders must work together and make their own contribution if the aim of reducing antimicrobial resistance is to be achieved. DART 2020, which is a joint strategy of the Federal Ministry of Health, the Federal Ministry of Food and Agriculture and the Federal Ministry of Education and Research, reflects this approach. Since antimicrobial resistance can spread beyond borders via commercial and passenger traffic, cooperation must not be limited to the national level. The framework for joint measures at the global level is provided by the Global Action Plan on Antimicrobial Resistance developed by the World Health Organisation (WHO) in conjunction with the World Organisation for Animal Health (OIE) and the UN Food and Agriculture Organisation (FAO). Germany has been instrumental in driving the adoption of the Action Plan and is keen to see it implemented in the near future.
6 DART 2020 – 2nd Interim Report 2017
With antimicrobial resistance already a focal point of Germany’s G7 pres-
idency, the subject has also been placed on the agenda of Germany’s G20
presidency. This underlines the importance of the problem and makes a
contribution to closer international cooperation. Germany has thus adopted a
pioneering role in the fight against antimicrobial resistance.
Aside from the key areas of infection prevention and the promotion of prudent
antibiotic use, this also includes stepping up research in this field. The devel-
opment of new antibiotics and enhanced diagnostics as well as improved
understanding of the emergence and spread of resistances count among the
essential contributions science can make to the fight against antimicrobial
resistance. In January 2017, the G20 agricultural ministers passed a decla-
ration and a respective action plan on the responsible use of antibiotics in
animal and plant production. To achieve a sustainable decline in antimicrobial
resistance, the problem must be addressed resolutely and at all levels. The
continued availability of effective antibiotics to combat infections in humans
and animals must be ensured.
Hermann Gröhe Christian Schmidt Prof. Dr. Johanna Wanka
Federal Minister of Federal Minister of Federal Minister of
Health Food and Agriculture Education and ResearchDART 2020 – 2nd Interim Report 2017 7
Introduction
In May 2015, the World Health Assembly (WHA) adopted the Global Action
Plan on Antimicrobial Resistance developed by the World Health Organisa-
tion (WHO) in conjunction with the World Organisation for Animal Health
(OIE) and the UN Food and Agriculture Organisation (FAO). The central
element of the Global Action Plan consists of the call on member states to
prepare multisectoral National Action Plans based on the One Health con-
cept within a period of two years.
Germany is leading the way with its Antimicrobial Resistance Strategy
(DART 2020) and is supporting the implementation of the Global Action
Plan. DART 2020 was developed jointly by the Federal Ministry of Health
(BMG), the Federal Ministry of Food and Agriculture (BMEL) and the Federal
Ministry of Education and Research (BMBF) and adopted by the Federal
Cabinet in May 20151.
Both the DART 2020 strategy and the measures contained therein are based
on the One Health concept according to which the problem of resistance and
the specific problems in human and veterinary medicine are approached on a
holistic basis. Key elements of DART 2020 include the promotion of prudent
antibiotic use and the raising of awareness among medical staff and the
general population. Further focal points consist of stepping up internation-
al cooperation, improving infection prevention, enhancing monitoring and
surveillance systems in the fields of antimicrobial resistance and antibiotic
consumption and promoting research and development.
In the context of its G7 presidency, Germany placed antimicrobial resistance
on the G7 agenda for the first time in 2015. As a result, the ‘Berlin Declara-
tion on Antimicrobial Resistance’2 was adopted in addition to the summit
declaration whose appendix contains important agreements on the subject of
antimicrobial resistance. Following the German presidency, the Japanese G7
presidency picked up the baton and established a technical task force at the
level of the Chief Veterinary Officers (CVO) which is set to focus, among other
subjects, on antimicrobial resistance. After China took up the issue last year
1 http://www.bundesgesundheitsministerium.de/fileadmin/Dateien/5_
Publikationen/Gesundheit/Berichte/BMG_DART_2020_Bericht_en.pdf
2 https://www.bundesgesundheitsministerium.de/fileadmin/Dateien/3_
Downloads/G/G7/G7_Gesundheitsminister_Erklaerung_AMR_Ebola_DE.pdf8 DART 2020 – 2nd Interim Report 2017
during its G20 presidency, Germany is continuing along this path during its
own G20 presidency in 2017.
The first report on the progress made under DART 2020 was published on
the occasion of the WHA 20163. This second report describes the progress
achieved through measures implemented at the national and international
levels and provides an outlook on the activities that have been planned for
the coming years.
In September 2016, the United Nations General Assembly repeated its call for
National Action Plans and issued a respective declaration, thereby committing
the highest political level of the UN to combating antimicrobial resistance.
Greater awareness of the problem of antimicrobial resistance and its impact
among heads of state and heads of government could make a major contribu-
tion to the swift implementation of the Global Action Plan.
GOAL 1: Strengthening the One
Health approach nationally and
internationally
Human and animal health must be approached together. Different sectors must
cooperate to contain the emergence and spread of antimicrobial resistance.
Close collaboration between all stakeholders and between the responsible
federal ministries and their subordinate authorities is essential. Due to the
globalised trade in animals and plants and expanding passenger traffic, close
coordination with international partners, not only in the EU but worldwide,
is a further prerequisite for long-term success. The implementation of the
Global Action Plan, which underlines the One Health approach, is a crucial
element.
3 http://www.bundesgesundheitsministerium.de/fileadmin/Dateien/3_
Downloads/D/DART_2020/DART2020_Zwischenbericht_2016.pdfDART 2020 – 2nd Interim Report 2017 9
Global Action Plan on Antimicrobial Resistance
The World Health Organisation (WHO) developed the Global Action Plan
on Antimicrobial Resistance in conjunction with the World Organisation for
Animal Health (OIE) and the UN Food and Agriculture Organisation (FAO).
The Plan was adopted by the World Health Assembly in May 2015. One of
its central demands is the development of multisectoral National Action
Plans by all members states by May 2017. Germany has led the way with the
DART 2020. The Global Action Plan aims to preserve the effectiveness of
antibiotics as long as possible. This requires quality assurance and respon-
sible use of antibiotics. At the same time, antibiotics must be accessible to
anyone who needs them. This overarching objective has been broken down
into five sub-goals:
1. Improve awareness and understanding of antimicrobial resistance
through effective communication, education and training.
2. Strengthen the knowledge and evidence base through surveillance
and research.
3. Reduce the incidence of infection through effective sanitation, hygiene
and infection prevention measures.
4. Optimize the use of antimicrobial medicines in human and animal
health.
5. Develop the economic case for sustainable investment that takes account
of the needs of all countries and to increase investment in new
medicines, diagnostic tools, vaccines and other interventions.
Progress so far
The problem of antimicrobial resistance was discussed at a high-level
meeting of the United Nations in September 2016. Germany was closely
involved in the preparation of the resulting political declaration. The activities
were pooled within the framework of the Action Package AMR of the Global
Health Security Agenda (GHSA). In conjunction with the UK, Netherlands,
Sweden, Canada and Japan, Germany assumed co-leadership of this Action
Package. A number of further countries are working on the same Action
Package. In 2016, the Action Package AMR focused on the preparation of the
Political Declaration of the UN General Assembly.10 DART 2020 – 2nd Interim Report 2017
In June 2016, the Codex Alimentarius Commission (CAC) resolved to set up an
AMR Task Force. Germany is an active member of this Task Force. A smaller
working group was set up to revise the project documents for the Task Force
and select the subject areas relevant to the call for the WHO and FAO to
provide scientific expertise in consultation with the OIE. The working group,
in which Germany also played an active role, has completed its tasks and the
CAC 2017 will vote on the working group’s documents.
United Nations General Assembly (UNGA)
The United Nations addressed the subject of antimicrobial resistance in the
context of a high-level meeting on 21 September 2016. The meeting aimed
to raise awareness of the problem of antimicrobial resistance among heads
of state and heads of government, especially in developing countries and
emerging nations, and thereby support the swift implementation of the Global
Action Plan.
In a joint Political Declaration, the member states once again committed
themselves to developing and implementing a national AMR strategy. The
Declaration also calls for the establishment of an Interagency Coordination
Group tasked with developing practical guidelines for sustainable global
action to combat antimicrobial resistance and ensuring closer cooperation.
The group was set up in March 2017.
Thanks to the continuous and determined commitment shown by Germany
and a few other member states, FAO declared that it would earmark regular
budget funds for the subject of antimicrobial resistance in its upcoming Pro-
gramme of Work and Budget (PWB 2018-19).
In September 2016, Germany and the UK hosted a side event on antimicrobial
resistance at a meeting of the FAO Committee on Agriculture (COAG). Under
the title of ‘Antimicrobial resistance: global implications’, the event added to
the momentum that had been launched by the recent Political Declaration of
the high-level AMR meeting of the UN General Assembly.
Building on ongoing international debates and developments, Germany is
working to advance the subject of antimicrobial resistance in the context
of its G20 presidency in 2017. The main objective is to discuss the issues
of infection prevention and the prudent use of antibiotics – based on the
One Health approach in both human and veterinary medicine – as well asDART 2020 – 2nd Interim Report 2017 11 incentive mechanisms designed to boost research and development of new antibiotics, alternative treatments and rapid diagnostics, and to recommend suitable action in the above-mentioned areas. In January 2017, the G20 agricultural ministers passed a declaration and a re- spective action plan on the responsible use of antibiotics in animal and plant production. They agreed that antibiotics should be classed as prescription drugs for animals. In addition, they concurred that each country should sub- mit either a national risk analysis focusing on safety or a roadmap outlining the phase-out of antibiotics as growth promotors by 2020. After antimicrobial resistance had been the subject of the founding meeting of the G7 CVOs in Tokyo, a sub-working group met in Rome in March 2017 during the Italian G7 presidency to determine joint definitions of relevant terms. This work is to be continued by a working group relying exclusively on electronic communication. In addition, Germany has further stepped up bilateral cooperation in the field of antimicrobial resistance. At the 5th German-Turkmen Health Forum, which took place in Ashgabat on 4/5 November 2016, attendants exchanged experi- ences with the national implementation of the Global Action Plan and forged closer ties. In addition, a close exchange took place with Sweden and Estonia. Since May 2016, projects combating AMR primarily in Africa and South-East Asia have been funded via the Global Health Programme set up by the Ger- man Federal Ministry of Health. Supported by the Robert Koch Institute (RKI) and the Federal Institute for Drugs and Medical Devices (BfArM), the projects aim to build global capacities to combat antimicrobial resistance and assist the implementation of the Global Action Plan. In specific, the projects focus on building capacities in the fields of laboratory diagnostics and surveillance, the impact and antimicrobial resistance profiles of infections in out-patient and in-patient care, promoting the prudent use of antibiotics and expanding the capacities of drug control laboratories. On top of this, Germany also funds projects set up by the WHO Regional Of- fice for Europe to help non-EU countries in Europe develop and implement national action plans. Furthermore, funds are provided in support of OIE projects aiming to combat zoonoses/antimicrobial resistance or ensure food security via animal health
12 DART 2020 – 2nd Interim Report 2017
measures particularly in southern Africa. These measures also contribute
towards strengthening global capacities.
Outlook
The fight against diseases that can be transmitted from humans to animals and
vice versa (zoonoses) represents a major challenge. At the national level, the
BMG’s planned ‘zoonoses’ funding priority will further promote cooperation
between the different areas. A respective announcement will be made in May
2017. In this context, the problem of resistant bacterial pathogens will also be
addressed.
Strengthening international capacities to combat antimicrobial resistance
requires a long-term approach. Germany will continue, and step up, its
cooperation with partner countries and its involvement in committee work at
international organisations in the coming years.
Under the new 2017 EU Action Plan on Antimicrobial Resistance, Europe is
set to turn into a best practice region with respect to the implementation of
the Global Action Plan. Germany will be closely involved in the preparation of
the action plan. This is to ensure the consideration of national distinctions as
well as close coordination with current activities (e.g. activities ensuing from
the G20 presidency).
In autumn 2017, a meeting of the G20 public health and veterinary public
health institutes is planned in Berlin during the German G20 presidency.
The practical implementation of measures will take priority. The meeting
will serve to establish networks between public health and veterinary public
health institutes at the G20 level. Subjects that equally concern both areas,
such as surveillance, prudent use of antibiotics and infection prevention, will
be discussed on the basis of real-life examples.
In 2017, the European Commission (EC) launched an initiative to improve co-
ordination between member states’ research and development activities in the
field of ‘One Health/zoonoses’ and to develop a respective joint programme.
In the context of the 2017 work schedule of its Horizon 2020 programme, the
Commission has called for tenders for its Societal Challenge no. 2 ‘Food secu-
rity, sustainable agriculture, marine and maritime research, and the bioecono-
my’ (SC2), which is to be funded through the new European Joint Programme
Cofund (EJP COFUND). The funding volume amounts to € 45 million.DART 2020 – 2nd Interim Report 2017 13 GOAL 2: Recognising changes in resistance at an early stage Representative data on the emergence of new and established pathogens and resistances are required to facilitate the adjustment of treatment and hygiene recommendations to the latest developments and assist the development of specific prevention strategies. Such data will also contribute towards adapt- ing the prescription behaviour among doctors. The development of resistance rates over time indicates the effectiveness of the measures taken. Progress so far The number of laboratories participating in RKI’s antimicrobial resistance surveillance (ARS) has risen continuously. Since 2010, the number of hos- pitals in the programme has tripled, while the number of surgeries rose by approx. 50 % in the last year. This expansion has also improved the database at the European and international levels. The WHO’s Global Antimicrobial Resistance Surveillance System (GLASS) was set up to facilitate standardised antimicrobial resistance surveillance as part of the implementation of the Global Action Plan. Validated, comparable data on antimicrobial resistance are collected and evaluated in support of specific measures. At the same time, GLASS helps verify progress in the implementation of the national surveillance systems. Germany is involved in the early introductory phase of GLASS and will thus contribute towards the identification of areas in need of adjustment. Resistance monitoring of animal pathogenic bacteria at the Federal Office of Consumer Protection and Food Safety (BVL) is continuing similar to resistance monitoring of zoonotic pathogens and commensals by the state authorities and Federal Institute for Risk Assessment (BfR). Commensals are organisms, for instance bacteria, which feed on the leftovers of their host organisms without damaging the latter. September 2016 saw the publication of GERMAP 2015, the fourth report on trends in antibiotic consumption and the spread of antimicrobial resistance in human and veterinary medicine in Germany. The report was published by the BVL and the Paul Ehrlich Society for Chemotherapy (PEG). It summa- rises the trends observed in the last years, thereby providing a basis for the
14 DART 2020 – 2nd Interim Report 2017
development of guidelines and recommendations for the antibiotic treatment
of infectious diseases among humans and animals.
The inclusion of the selective substantiation of ESBL/AmpC-producing and
carbapenemase-producing Enterobacteriaceae completed the adaptation
of resistance monitoring of zoonotic pathogens and commensals to new
EU legislation. In this context, the BfR established various methods for
studying Escherichia coli and Salmonella and substantiated the existence of
the first carbapenem resistance genes in animal isolates. In addition, studies
are being conducted to establish how these resistance genes, or pathogens
with the resistance genes, enter animal populations and their environment.
In the European Union, the use of antibiotics in the carbapenem class is not
permitted in animal treatment.
Outlook
In the context of infection events in Germany, the national reference centres
(NRZ) and consultant laboratories (KL) serve as early warning and reaction
systems. They focus primarily on the development or improvement of diagnostic
procedures for their assigned pathogens and their specific diagnostics as
well as their resistance and virulence aspects. Furthermore, the NRZ provide
consultancy services to public health authorities and the medical community.
Due to the high relevance of Clostridium difficile to public health, not least
in connection with antibiotics prescriptions, a dedicated C. difficile NRZ will
replace the previous KL by the end of 2017.
It is essential that data on infection events are transmitted swiftly from the
local level to the respective state and federal authorities. This requires a
uniform data collection and processing system. The creation of a respective
electronic reporting procedure (German Electronic Reporting System for In-
fection Prevention/DEMIS) and its mandatory use are currently being written
into German law.
The BfR will carry on its in-depth research into the factors that lead, or may
contribute, to the detection of carbapenem resistant genes in animal bacteria.DART 2020 – 2nd Interim Report 2017 15
GOAL 3: Retaining and improving
therapy options
The prudent use of antibiotics is essential if the effectiveness of antibiotics is
to be preserved in the long run. In Germany, antibiotic use varies from region
to region and from animal species to animal species. The reasons can be man-
ifold. To get a better understanding of the matter, data of antibiotic sales and
consumption volumes are required. These data also form the basis for specific
intervention measures and help assess their effectiveness.
Progress so far
The antibiotic consumption surveillance (AVS) established at the RKI in 2014
has expanded continuously. Last year, the number of laboratories in the pro-
gramme increased by approx. 30%. At present, 282 hospitals are part of AVS.
Among other objectives, the national antimicrobial resistance (ARS) and con-
sumption (AVS) surveillance systems aim to help hospitals implementing the
local antibiotic stewardship measures. A feasibility study funded by the BMG
is currently developing a model for the combined evaluation and provision of
resistance and consumption data. The pooling of data, their processing and
structured feedback is to support and advance the introduction and operation
of local antibiotic management.
In day-to-day hospital operations, infectiological guidelines are not always
implemented. The Commission on Anti-Infectives, Resistance and Therapy
(ART) has published a current policy document entitled ‘Prerequisites and
strategies for the successful implementation of infectiological guidelines’.
In this paper, the Commission proposes the introduction of infectiological
guidelines based on best practice examples and evidence-based intervention
strategies in in-patient and out-patient care4.
4 http://www.rki.de/DE/Content/Kommissionen/ART/Positionspapier/
Positionspapier_Leitlinien_Implementierung.html16 DART 2020 – 2nd Interim Report 2017
Commission on Anti-Infectives, Resistance and Therapy
The Commission on Anti-Infectives, Resistance and Therapy (ART) is an in-
dependent body of experts established in 2013 on the basis of the Infection
Prevention Act. It is the Commission’s task to issue recommendations on
standards relating to the diagnosis and treatment of infectious diseases ac-
cording to the current state of the art of medical science. On this basis, the
Commission performs a medical-epidemiological risk-benefit assessment
weighing the individual’s interest in effective treatment against the public
interest in the preservation of effective anti-infectives.
In addition, it examines existing recommendations and guidelines and
assesses the need for current guidelines in the fields of diagnostics and
therapy of infectious diseases. With respect to expert associations, other
scientific institutions and self-managing bodies, the Commission works to
promote compliance of recommendations and guidelines with the above
standards and the development or updating of respective guidelines. To
achieve this aim, the Commission analyses and evaluates data relating
to changes in the pathogen spectrum according to type and prevalence,
medical use of antimicrobial drugs and desired as well as undesired effects
including changing effects.
In the period 2011 to 2015, the total volume of antibiotics sold by pharma-
ceutical companies and wholesalers to veterinarians in Germany declined
by more than half from 1,706 tonnes to 805 tonnes (down 53 percent). In
the period 2014 to 2015, the total volume of antibiotics sold declined by
433 tonnes (down 35 percent). Sales volumes of antibiotics which are of
particular relevance to humans also recorded a slight decline.
The Veterinary Consumption of Antibiotics (VetCAb) project
This project aims to describe the consumption of antibiotics in farm
animals in Germany as well as providing a database for scientific analysis.
Consumption is measured by the average number of times a farm animal
is treated with antibiotics in Germany. On top of this, the project collects
data on types of active substances, their volumes and the frequency of their
application. In the long term, the data will be used to form an assessment of
the impact of antibiotic consumption on bacterial resistance to antibiotics
and provide a basis for recommendations of respective countermeasures to
prevent the development of further resistances.DART 2020 – 2nd Interim Report 2017 17 The Institute of Biometrics, Epidemiology and Information Processing of the University of Veterinary Medicine Foundation in Hanover is implementing the VetCAb project on behalf of the BfR; in the first few years, the Institute of Pharmacology, Pharmacy and Toxicology at the Faculty of Veterinary Medicine of the University of Leipzig was also involved. A study was conducted in 2007 and 2008 to assess the feasibility of a com- prehensive record of antibiotic consumption in Germany, which data could be used as a basis and how such data can be collected. As a next step, a pilot study was conducted in the period 2011 to 2013 which collected scientifi- cally representative data on nationwide antibiotic consumption for the first time. Since 2013, the project has been carried on by the VetCAb-Sentinel study which investigates the question whether the volume and frequency of the documented antibiotics remain constant over an extended period or change over time. Antibiotic minimisation concept The 16th amendment of the German Medicinal Products Act established a benchmarking system as a tool to minimise the use of antibiotics in farm animals. The system centres on comparative analysis of individual treatment frequencies in farms compared to average nationwide figures. The analysis is broken down into different farm animal species and age brackets. Where treatment frequencies of farms exceed the reference figure 1 or the reference figure 2, livestock owners are required to consult a veterinarian to establish the cause. Analysis of the cause may result in mandatory measures to reduce the consumption of antibiotics in the enterprise. The reduction of individual treatment frequencies lowers the nationwide figures calculated on the basis of the individual figures, making this a dynamic antibiotic minimisation system. The aim is to continuously reduce the nationwide use of these substances to the necessary minimum and hence curtail the development of antimicrobial resistance. The Federal Office of Consumer Protection and Food Safety (BVL) calcu- lates the nationwide figures twice a year, in March and September, and publishes them in the Federal Gazette.
18 DART 2020 – 2nd Interim Report 2017
Based on the white paper on further regulations relating to the use of antibio
tics in animals, a draft regulation amending the Veterinary House Dispensary
Ordinance was drawn up and discussed in detail with state governments and
associations.
Outlook
Among other purposes, the budget of the Innovation Fund (total annual
volume: € 300 million) is used to finance the innovative supply projects
entitled ‘Resistance prevention through adequate use of antibiotics in
respiratory tract infections’ (RESIST) and ‘Sustainable prevention of
antimicrobial resistance formation’ (ARENA). The ‘Converting Habits of
Antibiotics Use for Respiratory Tract Infections in German Primary Care’
(CHANGE-3) project is financed in the context of the Federal Ministry of
Health’s ‘Antimicrobial resistance and hospital-acquired infections’ funding
priority (cf. Goal 5). In the period until 2020, these research projects are
charged with identifying suitable measures to achieve prudent use of
antibiotics in out-patient care. The target group includes patients as well as
medical staff. This includes research into the impact of various measures on
antibiotic use.
Work on the regulation amending the Veterinary House Dispensary Ordi-
nance continues with the aim of reducing the use of antibiotics in animals,
especially antibiotics which are of special relevance to humans, via strict
regulations.
A report on the effectiveness of the antibiotic minimisation concept will be
submitted to the German Federal Parliament in April 2019.
GOAL 4: Breaking chains of infection
early and avoiding infections
Prevention of infections is the most effective instrument for reducing the
use of antibiotics. Compliance with hygiene measures by qualified hospital
staff and livestock owners is crucial. On top of this, up-to-date diagnostics
are essential if antibiotics are to be employed in a focused manner and the
spread of resistant pathogens is to be prevented. Regional networks promot-
ing the prevention and control of resistant infectious pathogens can makeDART 2020 – 2nd Interim Report 2017 19 an important contribution towards the identification and removal of local application barriers and implementation problems. Progress so far Diagnostics assist the focused use of antibiotics. The German government’s ‘pharma dialogue’ has furnished important stipulations that have now been written into law. The amendment of regulations on refunds for diagnostic procedures is creating the right conditions for enhanced use of diagnostics promoting swift and quality-assured antibiotic treatment in SHI care. In addition, the resistance situation will be given more weight in the pharma- ceuticals price formation system. Since January 2017, data reflecting the quality of out-patient and in-patient services in post-surgery wound infection prevention have been collected, subjected to comparative analysis and evaluated in compliance with the guideline issued by the Federal Joint Committee (G-BA) on ‘cross-institutional and cross-sector quality assurance: prevention of hospital-acquired infections (post-surgery wound infections)’. Principally, these data are to help determine and evaluate institution-specific wound infection rates after certain surgical interventions. In December 2016, the 5th meeting of facilitators of the regional networks for multi-resistant pathogens took place at the RKI in Wernigerode. Re- sponsible use of antibiotics was one of the key subjects of the meeting. The regional networks bring together various stakeholders, among them hospitals and registered doctors as well as retirement and care homes coordinated by the German Public Health Service (ÖGD). The aim is to adopt a joint approach and implement coordinated measures to prevent the emergence and spread of multi-resistant pathogens. A further objective is improved communication between the stakeholders. Regular meetings are used as opportunities to ex- change experiences. In addition, information material drawn up by individual networks can be shared via a protected website. The hygiene promotion programme, which was launched in 2013, has been extended until 2019 with the aim of helping hospitals meet the specialised hygiene staff requirements. Infectiology was added as a further subject. The programme offers financial support in the areas of recruitment, advanced training and consultancy services. A total of € 460 million have been ear- marked for the programme over its full term.
20 DART 2020 – 2nd Interim Report 2017
Committee for Hospital Hygiene and Infection Prevention (KRINKO)
The legal basis of the Committee for Hospital Hygiene and Infection
Prevention (KRINKO) is the Infection Prevention Act (IfSG). The Com-
mittee provides evidence-based recommendations on the prevention of
hospital-acquired infections and the managerial/organisational and con-
struction/functional aspects of hygiene measures in hospitals and other
medical institutions. Published by the Robert Koch Institute, the recom-
mendations are continuously refined on the basis of current infection
epidemiological evaluations.
Pursuant to the Infection Prevention Act, managers of medical institutions
are required to implement the measures necessary to fight hospital-acquired
infections according to the current state of the art of medical science. In this
field, compliance with the KRINKO recommendations is assumed to satisfy
the current state of the art of medical science.
At the beginning of each three-year term, KRINKO draws up a work sched-
ule which systematically addresses known problem areas. The schedule also
takes current epidemiological requirements into consideration.
Standing Vaccination Committee (STIKO)
The German Standing Vaccination Committee (STIKO), an independent
body of experts established by the Infection Prevention Act, develops
national vaccination recommendations. STIKO considers the benefits of
vaccinations both at the individual level and in terms of public health.
Recommendations are given according to the criteria of evidence-based
medicine. While effectiveness (mostly in comparison to placebos), safety
and pharmaceutical quality are decisive for the approval of vaccinations,
STIKO also uses these data as a basis to study individual risk-benefit ratios,
the epidemiology at the public health level and the effects of a nationwide
vaccination strategy for Germany. Furthermore, STIKO develops criteria to
distinguish between common vaccine reactions and health damage that
goes beyond the usual extent. STIKO recommendations are considered
medical standards.
Infection prevention was a priority subject at the second international Patient
Safety Summit which took place in Germany in March 2017. The UK andDART 2020 – 2nd Interim Report 2017 21 Germany joined forces to set up this international conference of ministers which will now take place on a regular basis. At the second summit, infection prevention was primarily discussed in the context of hospital-acquired infec- tions and sepsis and with reference to curtailing the general need for antibiotics as a means of preventing resistances. Core messages were drawn up at an expert workshop and refined within the framework of a meeting of ministers. It emerged that hospital-acquired infections and sepsis have a significant impact. Both can be reduced through infection prevention and control programmes. The WHO has developed respective recommendations. Further essential factors are standardised monitoring and feedback on infection prevention measures. All of these measures should be patient-centred and cost-effective. In autumn 2016, the German Veterinary Society (DVG) completed the de- velopment of standardised protocols used to verify resistance for seven key pathogens in farm animal husbandry. The project was funded by the BMEL. Its results were used to adapt the layout of microwell plates used to examine the susceptibility of animal pathogens with the broth microdilution method. These DVG recommendations are to help encourage the sale of microwell plates in larger batches and thus promote their cost-effective use in routine diagnostics. Funded by the BMEL Innovation Promotion programme, a project was launched to develop an innovative broiler husbandry system (fitavis) to raise hygiene in coops and reduce infection and recontamination risks during the fattening period. This approach improves animal health and helps curtail the use of antibiotics during the fattening period. A further research project (Reduced use of antibiotics in pig production through integration of epidemiological information from clinical, hygienic, microbiological and pharmacological veterinary consulting, VASIB in short) investigates various options of optimising veterinary consulting services using the example of respiratory tract diseases in pigs. The project aims to establish whether specific diagnostic measures and in-depth, comprehensive manage- ment consulting can lead to improved treatment strategies and the mini- misation of antibiotic use. Furthermore, the development and validation of software suitable for veterinary surgeries is to pool epidemiological data from preventative veterinary medicine with agricultural operations data. Based on this data pool, ongoing consulting services will be provided to agricul- tural enterprises and the development of resistances in bacterial pathogens of respiratory tract infections in correlation to the use of antibiotics will be
22 DART 2020 – 2nd Interim Report 2017
traced along the entire production chain. The results will serve as the basis
for applied agricultural training and teaching concepts.
Outlook
In 2016, the German Charité Institute for Hygiene and Environmental Medi-
cine participated in the second Point Prevalence Survey of Healthcare-Asso-
ciated Infections and Antimicrobial Use conducted by the European Centre
for Disease Prevention and Control (ECDC). In autumn 2016, Germany also
took part in a Point Prevalence Survey in the context of the ‘Healthcare-As-
sociated Infections in European Long-Term Care Facilities (HALT-3)’ project.
The evaluated survey results will yield data that can be used to assess the
effectiveness of current regulations and recommendations.
In 2018, the third Patient Safety Summit will take place in Japan. Germany
will attend the summit and contribute to an agreement on further concrete
measures.
Research projects on interrupting infection chains between animal popula-
tions and along the food chain, which have been launched in the veterinary
field, will be continued.
GOAL 5: Raising awareness and
strengthening skills
The prudent use of antibiotics and treatment of multi-resistant pathogens
requires specific knowledge. A significant need for information and sub-
stantial gaps in knowledge are prevalent not only among the population but
also among medical and veterinary professionals and livestock owners. This
situation must be remedied.
Progress so far
In the past, extensive information material on the prudent use of antibiotics
and on antimicrobial resistance and its consequences was developed and
distributed by various institutions, among them the Federal Centre for Health
Education (BZgA).DART 2020 – 2nd Interim Report 2017 23 Over the next three years, the ‘Converting Habits of Antibiotics Use for Respira- tory Tract Infections in German Primary Care’ (CHANGE-3) project launched by the BMG under its ‘Antimicrobial resistance and hospital-acquired infections’ funding priority will, inter alia, investigate the effectiveness of a comprehen- sive public information campaign, which is to raise awareness of antimicrobial resistance and prudent antibiotic use among the population (insured individ- uals, patients, relatives). The project is considering various media as potential information carriers. It is the aim of the campaign to provide all individuals with sufficient competence to involve themselves in the decision for or against anti- biotic treatment and thereby, ultimately, reduce the consumption of antibiotics. In the course of the amendment of the German Regulation Pertaining to the Licensing of Veterinarians (TAppV), resistance development risks were included in the pharmacology and toxicology examination subject. Thus, the impact of the prescription of antimicrobial drugs is already highlighted at the veterinary training stage and responsible use of antibiotics is promoted. VetMAB – joint project promoting the development and introduction of an Internet-based training and data management tool to minimise the use of antibiotics in farm animal husbandry VetMAB is an e-learning course funded by the BMEL and recognised by the Academy of Advanced Veterinary Training that gives veterinarians access to advanced training in the fields of resistance emergence and spreading as well as current test procedures. The course consists of one basic module and a number of species-specific advanced modules. All modules offer exer- cises based on model agricultural enterprises and provide opportunities for the interactive discussion of problems. On top of this, a chat room has been set up for the participants. A further key element is the resistance monitoring tool – a database system including interfaces with surgery management programs. The tool can be used to archive resistance test results and record individual resistance situ- ations of the bacteria found in the agricultural enterprises under the care of the participating veterinarians. It also offers interpretation aids. The registe- ring veterinarians determine who can view and use these data. Veterinarians participate via a website that also provides current information as well as legal regulations and reports on the subject of antimicrobial resistance. In addition, participating veterinarians can seek advice on specific issues.
24 DART 2020 – 2nd Interim Report 2017
Outlook
The enhancement of basic and advanced training in the field of antimicrobial
resistance will remain a central element of the implementation of DART 2020.
For this purpose, the BMG maintains close links with expert societies and the
German Medical Association. Expert talks are planned for the year 2018.
Every two years, the Robert Koch Foundation presents a hospital hygiene
award. The award is conferred for outstanding scientific work and prac-
tical measures in the field of hospital hygiene and infection prevention.
The Federal Ministry of Health, which funds the Robert Koch Foundation,
is involved in the selection of the award winners. In September 2017, the
award will be presented for the third time. In the area of practical hospital
procedures, this provides an incentive to make improved workflows avail
able to the public as best practice examples.
VetMAB II5 will continue to promote the Internet-based training and data
management tool to minimise the use of antibiotics in farm animal husband-
ry. New objectives consist of the introduction of a basic module for farmers
and a module for practising veterinarians and farmers outlining the objectives
pursued by action plans to reduce antibiotic use pursuant to the requirements
of the Medicinal Products Act, including their structure, as well as a module
for veterinarians in the public sector outlining specialised knowledge in the
field of appraising and evaluating measures. In addition, exchanges between
the three groups will be encouraged.
GOAL 6: Supporting research
and development
Research makes an essential contribution towards gaining the knowledge nec-
essary to develop enhanced diagnostics and identify new anti-infective agents.
DART 2020 therefore endeavours to strengthen all respective research areas
in both human and veterinary medicine, from fundamental research, clinical
research and public health issues to research in conjunction with the health,
agriculture and food industries. Aside from the need for a better understand-
ing of the emergence and spread of resistances, there is also an urgent need
5 https://www.vetmab.de/DART 2020 – 2nd Interim Report 2017 25 for new drug candidates. Nationally and internationally coordinated initiatives are encouraging research and development in the field of anti-infectives. Progress so far In October 2016, a meeting of the global expert network, which had been set up in 2015 during the German G7 presidency, took place in Berlin. Over 130 inter- national experts in the fields of science, pharmaceutical industry, human and veterinary medicine, regulation authorities, the European Union and internation- al organisations, including the WHO and the OIE, met on the occasion. Based on the One Health approach, workshops discussed strategies for the improvement of innovations in antibiotic research and development, antibiotic use at the in- terface between human and veterinary medicine and the preparation of a list of resistant pathogens by the WHO. The list, which has meanwhile been published by the WHO, specifies the pathogens that currently pose the greatest threat to human health. It is to act as a guidepost for research and development. At the fourth workshop, the ‘Global Antibiotic Research and Development Partnership (GARDP)’ presented initial projects relating to the ‘Drug Combination Platform & Antibiotic Memory Recovery initiative (AMRi)’ as well as to gonorrhoea and sepsis in new born infants. Germany made a financial contribution during the GARDP founding phase and continues to support the partnership in 2017. Global Antibiotic Research and Development Partnership (GARDP) The Global Antibiotic Research and Development Partnership (GARDP) is a non-profit research and development organisation set up by the WHO and the ‘Drugs for Neglected Disease Initiative (DNDi)’ in 2016. Its objectives consist of research and development of new antibiotics and simultaneous promotion of prudent antibiotic use. This also includes the issue of access to antibiotics. Three of the programmes focus on specific issues, namely sepsis in newborn infants, sexually transmitted diseases and antibiotics in paediatric medicine. The fourth programme concentrates on overarching aspects, among them the introduction of a platform to safeguard research results which can be used for future approaches. Supporting GARDP also advances the implementation of the Global Ac- tion Plan on Antimicrobial Resistance which calls for new public-private partnerships to promote research and development of new antibiotics and diagnostics.
26 DART 2020 – 2nd Interim Report 2017
In 2015, the G7 health ministers also agreed to support the continuous record-
ing, evaluation and joint definition of the most dangerous global pathogens.
In response to a request by the BMG, the WHO has prepared a global list
of multi-resistant bacterial pathogens which was published at the end of
February 2017. The list is to serve as a guide for new antibiotic research and
development, alternative treatment options and diagnostics.
‘Breaking through the Wall – A Call for Concerted Action on Antibiotics
Research and Development’ – a follow-up appraisal drawn up by order of the
Federal Ministry of Health – was submitted at the beginning of 20176. The
first appraisal had been prepared in 2015 under the German G7 presidency.
The follow-up appraisal contains suggestions for the practical implementa-
tion of incentive mechanisms to advance research and development in the
fields of new antibiotics, alternative treatments and diagnostics.
Taking over an assignment from the Chinese G20 presidency7, the German
government used its own G20 presidency to commission the OECD, in
conjunction with the WHO, FAO and OIE, to draw up a report entitled
‘Tackling Antimicrobial Resistance, Ensuring Sustainable R&D’ which contains
recommendations for action the G20 can take to combat antimicrobial
resistance and proposes strategies to boost the development of new
antibiotics. The OECD report is to be submitted at the G20 Summit in
Hamburg at the beginning of July.
The BMG-funded project ‘Evaluation of wastewater treatment techniques
promoting the reduction of clinically relevant infectious pathogens and de-
terminants of antimicrobial resistances (REDU-Antiresist)’ studied the impact
of wastewater treatment techniques on the spread of antimicrobial resistance
through wastewater from hospitals. The results may provide an important
impetus to the development of recommendations regarding wastewater
treatment methods, especially in the area of hospital wastewater.
Scientists at non-university research institutes run by the Max Planck Society,
the Helmholtz Association, the Leibniz Association, the Fraunhofer Society
and the German Health Research Centres are also studying antimicro
bial resistance. These institutes include the Helmholtz Centre for Infection
6 http://www.bundesgesundheitsministerium.de/fileadmin/Dateien/5_
Publikationen/Gesundheit/Berichte/GUARD_Follow_Up_Report_Full_Report_
final.pdf
7 http://www.fmprc.gov.cn/mfa_eng/zxxx_662805/t1395000.shtmlDART 2020 – 2nd Interim Report 2017 27 Research (HZI) and the Helmholtz Institute for Pharmaceutical Research (HIPS) in Saarbrücken, the German Center for Infection Research (DZIF), the Max Planck Institute for Infection Biology (MPI-IB) and the Leibniz Institute for Natural Product Research and Infection Biology – Hans Knöll Institute (HKI). Over the last few years, the HZI has systematically expanded its research activities in the field of new antibiotics. The institute is researching antibio tics with new, resistance-breaking modes of action. Primarily, it investigates active agents that occur in nature, optimises such agents and prepares them for future use as pharmaceuticals. Following their development of a pipeline to identify new antibiotic active agents, the HZI researchers discovered a number of novel antibiotic candidates, among them cystobactamides and amidochelocardins, which are effective against particularly resistant gram-negative pathogens. In conjunction with partners in the pharmaceu- tical industry, the researchers recently analysed and explained the mode of action of griselimycin, an agent active against multi-resistant tuberculosis pathogens. To step up the HZI’s efforts in the field of antibiotic research, the new build- ing of the Helmholtz Institute for Pharmaceutical Research Saarland (HIPS) in Saarbrücken was put into service in 2016. The institute also applies medical chemistry methods to address the problem of antimicrobial resistance based on promising target structures. A new HZI active agent and functional genome research centre, whose key research areas will include translational antibiotic research and larger-scale production of natural agents, is currently under construction. The DZIF is conducting an antibiotic treatment optimisation study (ATHOS) which focuses on the implementation of an antibiotic steward- ship (ABS) programme in doctors’ surgeries and hospitals based on existing guidelines. The aim is to optimise antibiotic use and assess the impact of the ABS programme on the spread of multi-resistant pathogens at the participating clinics. The study primarily concentrates on third-generation cephalosporin-resistant enterobacteriaceae (3GCREB) and vancomycin- resistant enterococci. The DZIF is conducting several studies which monitor the spread of multi- resistant pathogens in hospitals. Key results: In a nationwide study on 3GCREB, researchers found that patients were responsible for introducing
28 DART 2020 – 2nd Interim Report 2017
just under ten percent of the multi-resistant pathogens found in hospitals.
Escherichia coli bacteria, which produce beta lactamases – so-called ESBL
Enterobacteriaceae –, were exceptionally frequent. A Europe-wide study also
showed that particularly dangerous multi-resistant intestinal bacteria, such
as Escherichia coli or Klebsiella pneumoniae, are increasingly resistant against
carbapenem, an antibiotic of last resort. The DZIF employs state-of-the-art
genome sequencing methods to help monitor the global spread of multi-
resistant and extremely resistant tuberculosis bacteria.
Scientists at the non-university research institutions are also successfully
involved in projects in the BMBF’s temporary funding programme. One exam-
ple is InfectControl2020 – a consortium of academic and industry partners
that develops new anti-infective strategies. The project also provides impetus
for further economic development in the new federal states. Its coordination
is in the hands of the Leibniz Institute for Natural Product Research and
Infection Biology – the Hans Knöll Institute in Jena.
The BMBF is funding a collaborative research project entitled ‘Biological and
hygiene-medical relevance and control of antibiotic-resistant pathogens in
clinical, agricultural and communal wastewater and their impact on untreated
water (HyReKA)’ whose participants include scientists from various research
institutions as well as water suppliers and wastewater disposal companies,
industrial partners and authorities. The project is headed by the Institute for
Hygiene and Public Health at Bonn’s University Hospital. It researches the
spread of resistant pathogens through wastewater from hospitals, communal
areas, animal fattening and slaughter businesses and airports, and analyses
suitable counter-strategies.
The joint HyReKA project is part of the BMBF funding initiative entitled ‘Risk
management of new toxins and pathogens in the water cycle (RiSKWa)’ under
the ‘Sustainable Water Management (NaWaM)’ funding priority.
The newly established Center for Sepsis Control and Care, CSCC, has outstand-
ing expertise in the field. Antimicrobial resistance is a particularly obstructive
factor in the treatment of sepsis. Increasing susceptibility to resistant patho-
gens is jeopardising the swift antibiotic action required by sepsis patients.
The ‘Clinical studies with high relevance to patient care’ funding priority
finances multi-centric, prospective and controlled clinical studies researching
evidence of treatment effectiveness. This research is to close evidence gapsDART 2020 – 2nd Interim Report 2017 29 and pave the way for the integration of research results into patient care. The respective invitations for tenders are open to a wide range of subject areas. Furthermore, funding is also provided to several antibiotic treatment studies due to their high relevance to patient care. For instance, it has been shown that the use of antibiotics in the treatment of uncomplicated urinary tract infections can be substantially reduced through symptomatic treatment with Ibuprofen. In the context of the ‘Zoonotic infectious diseases’ funding priority, the BMBF has financed research into the transmission of resistant bacteria between hu- mans and animals conducted by two consortia (RESET and MedVetStaph). In April 2017, on conclusion of the funding period, the two consortia organised a joint symposium at the BfR in Berlin. Successful collaboration between project and institutional funding (RESET and DZIF) As an interdisciplinary research consortium, RESET primarily focuses on specific resistance mechanisms occurring in Enterobacteriaceae Escherichia coli and Salmonella enterica. In collaboration with the DZIF (in particular the Institute of Medical Microbiology at the DZIF’s Gießen site), the project partners compiled an extensive collection of microbial strains in the context of various studies researching the spread of such pathogens in animals, food and humans. Information regarding the origin of the samples and the re- sults of the respective laboratory tests were collated in a joint database. For in-depth study, the Institute of Medical Microbiology in Gießen sequenced the genome of a selection of the microbial strains. The sequencing data allowed the scientists to substantiate the existence of the newly discovered resistance gene mcr-1 against colistin (widely used for animal treatment) in three pig isolates which had been collected since 2011, as well as in one human multi-resistant isolate from the year 2014. The scientists also discov- ered other resistance genes in all four mcr-1-carrying isolates, which further restricts antibiotic treatment options. Hence, the research consortium and the DZIF were the first to provide evidence that the resistance gene mcr-1 occurs in Escherichia coli in farm animals as well as in humans in Germany, suggesting the possibility of transmission between animals and humans.
You can also read